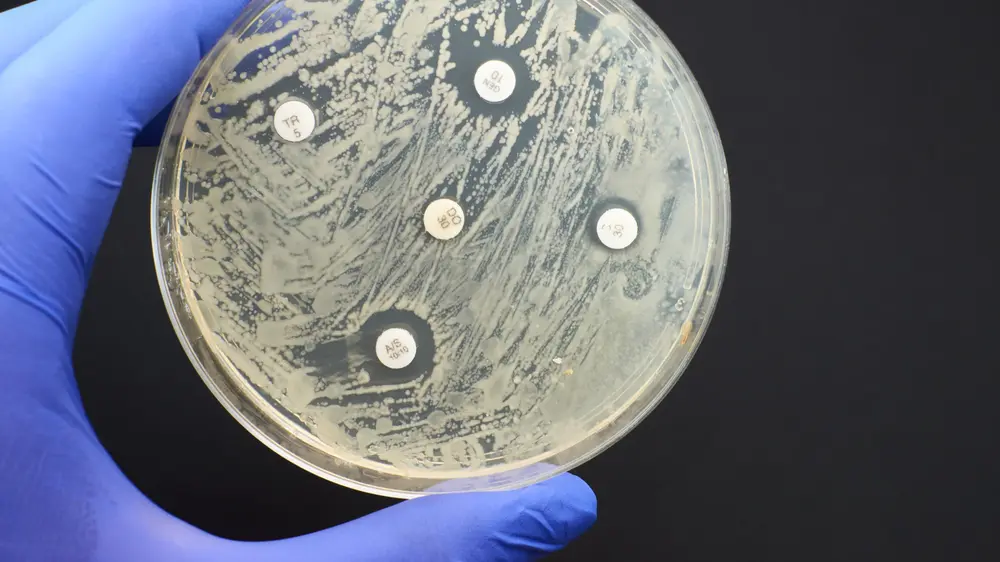

22/11/2025
À l’occasion de la Semaine mondiale pour la sensibilisation à l’antibiorésistance 2025, les autorités sanitaires belges dressent un état des lieux des avancées et des lacunes du Plan d’action national contre la résistance aux antimicrobiens (NAP AMR)

19/11/2025
En 2024, 662 nouveaux diagnostics d’infection par le VIH ont été posés en Belgique, soit une moyenne de 1,8 nouveau cas par jour. Le nombre de nouveaux cas, qui diminuait régulièrement avant le covid, remonte ces dernières années, rappelle Sciensano.

18/11/2025
Les personnes ayant contracté le mpox sont probablement protégées à long terme contre une réinfection, selon une étude de l'Institut de Médecine Tropicale (ITG) publiée mardi dans The Lancet Infectious Diseases.

18/11/2025
La vente totale d'antibiotiques à usage vétérinaire a baissé de 59,9 % en Belgique depuis 2011, ressort-il de chiffres publiés à l'occasion de la Semaine mondiale pour un bon usage des antibiotiques.

17/11/2025
Une personne a été infectée par le virus de la grippe aviaire de sous-type H5N5 aux États-Unis. Il s'agit d'un homme originaire de la région de Grays Harbour, dans l'État de Washington. Première fois que cette souche est détectée chez un humain.

13/11/2025
Pour la première fois depuis le début des années 1990, des traces de poliomyélite infantile ont été détectées dans un échantillon d'eaux usées prélevé près de Hambourg, en Allemagne.

10/11/2025
Le Canada est actuellement confronté à une importante épidémie de rougeole qui touchent plusieurs régions du pays. Il a dès lors perdu son statut de pays ayant éliminé cette grave, annonce le ministère canadien de la Santé.

06/11/2025
Une étude menée par Thijs Reyniers (Institut de médecine tropicale d'Anvers) révèle un fort engouement pour la PrEP injectable à action prolongée parmi les hommes belges ayant des relations sexuelles avec des hommes.

06/11/2025
Malgré les succès du contrôle de la transmission verticale du VIH, une génération d’adultes infectés durant l’enfance ou l’adolescence émerge. Leur santé mentale et leurs parcours socio-économiques diffèrent des personnes infectées à l'âge adulte.

06/11/2025
Substituer l’inhibiteur de l’intégrase par la doravirine, avec ou sans substitution simultanée du TAF par le TDF, n’a permis de modifier ni le profil lipidique, ni l’insulinorésistance, ni la composition corporelle après 48 semaines de suivi

05/11/2025
Présentées dans le cadre du congrès de l’EACS 2025, de nouvelles données de l’étude PASO-DOBLE apportent des arguments supplémentaires en faveur de la thérapie duale associant dolutégravir/lamivudine (DTG/3TC).

05/11/2025
Les données présentées mettent en évidence un risque accru et des diagnostics plus tardifs concernant plusieurs cancers chez les personnes vivant avec le VIH, et le constat d’une moindre adhérence aux recommandations de dépistage.

05/11/2025
Une sous-analyse de la cohorte RELATIVITY apporte de précieuses données en conditions de vie réelle sur l’efficacité, la tolérance et la persistance du CAB+RPV LA injectable au sein de cette population spécifique.

27/10/2025
Les personnes vivant avec le VIH qui bénéficient d’un traitement antirétroviral efficace et dont la charge virale est durablement indétectable peuvent vieillir sans perte notable de qualité de vie, tant sur le plan physique que mental, par rapport à la population générale.

23/10/2025
Dans le cadre de la lutte contre la résistance aux antibiotiques, l’Inami et le SPF Santé publique, en collaboration avec la KU Leuven, lancent une étude pilote pour évaluer un nouvel outil d'aide à la décision.

17/10/2025
Une étude de l'Institut de médecine tropicale (IMT) publiée dans la revue Scientific Reports indique que les résidus d'antibiotiques, légalement autorisés, dans les aliments pourraient être responsables de la résistance aux antibiotiques.

15/10/2025
Cinq ans après le Covid-19, le Global Preparedness Monitoring Board (GPMB) rapporte que malgré les progrès scientifiques et technologiques, le monde reste profondément vulnérable face aux prochaines pandémies.

15/10/2025
Lors d’une table ronde organisée le 14 octobre à Bruxelles, MSF a appelé les pays de l’Union européenne (UE) «à prendre des mesures urgentes face à la crise croissante de la prise en charge de la tuberculose.

13/10/2025
La résistance aux antibiotiques a augmenté de 40% en cinq ans au niveau mondial, révèle un rapport publié lundi par l'Organisation mondiale de la Santé (OMS). Cette tendance inquiétante conduit à l'existence d'un nombre croissant de "super bactéries" résistantes aux traitements classiques.
24/09/2025
Pour la première fois depuis 2017, l'OMS a mis à jour son classement des bactéries résistantes aux antibiotiques. Les bactéries à Gram négatif restent au sommet de la liste, tandis que des pathogènes communautaire gagnent rapidement du terrain.